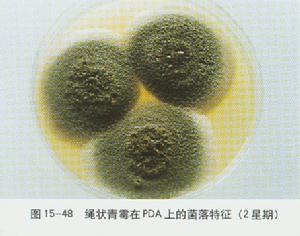
青酶菌

青酶菌青黴屬[Penicillium,X=2(P.species)]真菌的一種。半知菌類,串珠霉目的一屬。間有性生殖階段。菌絲為多細胞分枝。無性繁殖時,菌絲髮生直立的多細胞分生孢子梗。梗的頂端不膨大,但具有可繼續再分的指狀分枝,每枝頂端有2-3個瓶狀細胞,其上各生一串灰綠色分生孢子。分生孢子脫落後,再適宜的條件下萌發產生新個體。有性繁殖絕無僅有,如有發現,多歸於子囊菌綱麴黴科。常見於腐爛的水果、蔬菜、肉食及衣履上,多呈灰綠色。亦能引起柑橘的青黴病。有些種類如點青黴(P.notatum)和黃青黴(P.chrysogenum)等可提取青黴素,灰黃青黴(P.griseofulvum)等可提取灰黃黴素。
青酶菌青黴屬[Penicillium,X=2(P.species)]真菌的一種。半知菌類,串珠霉目的一屬。間有性生殖階段。菌絲為多細胞分枝。無性繁殖時,菌絲髮生直立的多細胞分生孢子梗。梗的頂端不膨大,但具有可繼續再分的指狀分枝,每枝頂端有2-3個瓶狀細胞,其上各生一串灰綠色分生孢子。分生孢子脫落後,再適宜的條件下萌發產生新個體。有性繁殖絕無僅有,如有發現,多歸於子囊菌綱麴黴科。常見於腐爛的水果、蔬菜、肉食及衣履上,多呈灰綠色。亦能引起柑橘的青黴病。有些種類如點青黴(P.notatum)和黃青黴(P.chrysogenum)等可提取青黴素,灰黃青黴(P.griseofulvum)等可提取灰黃黴素。代謝類型
 青酶菌孢子青黴菌屬於叢梗孢科。菌絲體由多數具有橫隔的菌絲所組成,通常以產生分生孢子進行繁殖,產生孢子時,菌絲體頂端產生多細胞的分生孢子梗,梗的頂端分枝2—3次,每枝的末端細胞分裂成串的分生孢子,形成掃帚狀。分生孢子一般呈藍綠色,成熟後隨風飛散,遇適宜環境,萌發成菌絲。青黴菌的種類很多,通常生於柑桔類水果上。蔬菜、糧食、肉類、皮革和食物上也常有分布。如產黃青黴PenicilliumchrysogenumThom、特異青黴P.notatumWestling均能產生青黴素。黃綠青黴P.citreo-virideBiourge、桔青黴P.citrinumThom和島青黴P.islandicumSopp能引起大米霉變,產生“黃變米”,它們產生的毒素如黃綠青黴素(citre—oViridin)對動物神經系統有損害,桔青黴素(citrinin)能損害腎,島青黴產生的黃天精、環氯素和島青黴素均為肝臟毒。
青酶菌孢子青黴菌屬於叢梗孢科。菌絲體由多數具有橫隔的菌絲所組成,通常以產生分生孢子進行繁殖,產生孢子時,菌絲體頂端產生多細胞的分生孢子梗,梗的頂端分枝2—3次,每枝的末端細胞分裂成串的分生孢子,形成掃帚狀。分生孢子一般呈藍綠色,成熟後隨風飛散,遇適宜環境,萌發成菌絲。青黴菌的種類很多,通常生於柑桔類水果上。蔬菜、糧食、肉類、皮革和食物上也常有分布。如產黃青黴PenicilliumchrysogenumThom、特異青黴P.notatumWestling均能產生青黴素。黃綠青黴P.citreo-virideBiourge、桔青黴P.citrinumThom和島青黴P.islandicumSopp能引起大米霉變,產生“黃變米”,它們產生的毒素如黃綠青黴素(citre—oViridin)對動物神經系統有損害,桔青黴素(citrinin)能損害腎,島青黴產生的黃天精、環氯素和島青黴素均為肝臟毒。種類特點
青黴菌是屬於麴黴科青黴屬。種類很多,分布很廣,其中訐多菌株均能引起食品的霉爛,也有不少菌株能產生強烈的毒素。黃綠青黴、桔青黴、冰島青黴、擴展青黴、鮮綠青黴等,它們所產生毒素的毒性作用各異。
桔青黴素:是一種能殺滅革蘭氏陽性菌的抗生素,因其毒性太強,未能用於治療。
 大腸桿菌本毒素主要得之於桔青黴、黃綠毒霉、鮮綠青黴等,它是“黃變米”中的黴菌毒素之一。桔青黴素為黃色針狀結晶。主要污染大米、小麥,大麥、燕麥和黑麥等。桔青黴素對小鼠經口LD50為110mg/kg。具有腎毒性,可使腎臟腫大、腎小管擴張、變性和壞死,有致突變性。
大腸桿菌本毒素主要得之於桔青黴、黃綠毒霉、鮮綠青黴等,它是“黃變米”中的黴菌毒素之一。桔青黴素為黃色針狀結晶。主要污染大米、小麥,大麥、燕麥和黑麥等。桔青黴素對小鼠經口LD50為110mg/kg。具有腎毒性,可使腎臟腫大、腎小管擴張、變性和壞死,有致突變性。冰島青黴毒素(1slanditoxin):由冰島青黴產剩,是“漚黃米”或“黃粒米”的主要原因。“漚黃米”是稻穀未及時脫粒乾燥而堆放,致使霉變.曳槓罕恍粒變黃。該毒素為含氯環狀結構的肽類,無色針狀結晶。有快速肝毒性,染毒後短時間內即可引起肝臟空泡變性、壞死和肝小葉出血;小劑量長時間攝人,可使小鼠肝硬變、乾纖維化和癌變。
黃綠青黴紊(Citreoviridin):由黃綠青黴等產生,也是“黃變米”中的黴菌毒素之一。它是深黃色針狀結晶。它具有神經毒、肝毒性和血液毒。其神經毒具有嗜中樞性。其慢性毒性主要表現於肝細胞萎縮和多形性及貧血。
檢驗方法
桔青黴:本菌屬於不對稱青黴菌,絨狀青黴亞群,桔青黴系群。在
青酶菌
青酶菌 青酶菌孢子
青酶菌孢子 大腸桿菌
大腸桿菌